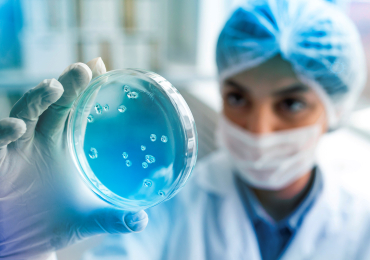
about images

Resrach And Development
You are here : Home / Resrach And Development
Research & Development at DPRLabz
At DPRLabz, Research & Development is more than a department—it's the heart of our organization. We are committed to pushing the boundaries of pharmaceutical science to discover, design, and deliver therapies that make a real difference in people's lives. Our R&D team brings together a diverse group of scientists, clinicians, and data specialists working collaboratively across disciplines to tackle some of the most complex challenges in healthcare.
We take pride in our science-driven approach, which combines traditional pharmacological expertise with next-generation technologies such as AI-powered drug discovery, bioinformatics, high-throughput screening, and predictive modeling. These capabilities enable us to accelerate early-stage development, reduce attrition rates, and improve the precision of targeted therapies.
Read more
Where Discovery Meets Development
At DPRLabz, our R&D efforts are guided by one central goal: to create therapies that improve lives and redefine what’s possible in medicine.
-
Research-Driven Innovation
DPRLabz is a science-first pharmaceutical company, dedicated to discovering and developing novel therapeutics through cutting-edge research and advanced technologies.
-
Advanced R&D Infrastructure
Equipped with modern laboratories, AI-integrated platforms, and a team of multidisciplinary experts, our facilities support drug development from concept to clinic.

-
Robust Drug Development Pipeline
We maintain a strong pipeline of preclinical and clinical-stage candidates aimed at solving unmet medical needs and improving patient outcomes globally.

-
Patient-Centric Mission
Every project at DPRLabz is rooted in our mission to develop life-changing therapies that are accessible, effective, and driven by real-world patient needs.

-
Regulatory & Clinical Excellence
We follow strict regulatory standards and manage clinical trials with precision, ensuring safety, compliance, and efficacy at every stage of development.

-
Robust Drug Development Pipeline
We maintain a strong pipeline of preclinical and clinical-stage candidates aimed at solving unmet medical needs and improving patient outcomes globally.

Where Science Ignites Tomorrow’s Therapies
Our agile development model ensures rapid iteration, adaptive trial design, and data-driven decisions—bringing therapies to patients faster.

At DPRLabz, we believe the best science happens through collaboration. We partner with academic institutions, biotech innovators, and global research networks to accelerate breakthroughs from bench to bedside.

At DPRLabz, innovation is powered by precision. Our state-of-the-art infrastructure is designed to support the entire drug development lifecycle — from early discovery to clinical trials — with speed, accuracy, and regulatory excellence.

Our multidisciplinary R&D team, comprising scientists, clinicians, and regulatory experts, upholds the highest standards of scientific integrity, safety, and compliance. Every molecule we develop reflects our commitment to evidence-based innovation and patient-centric care.